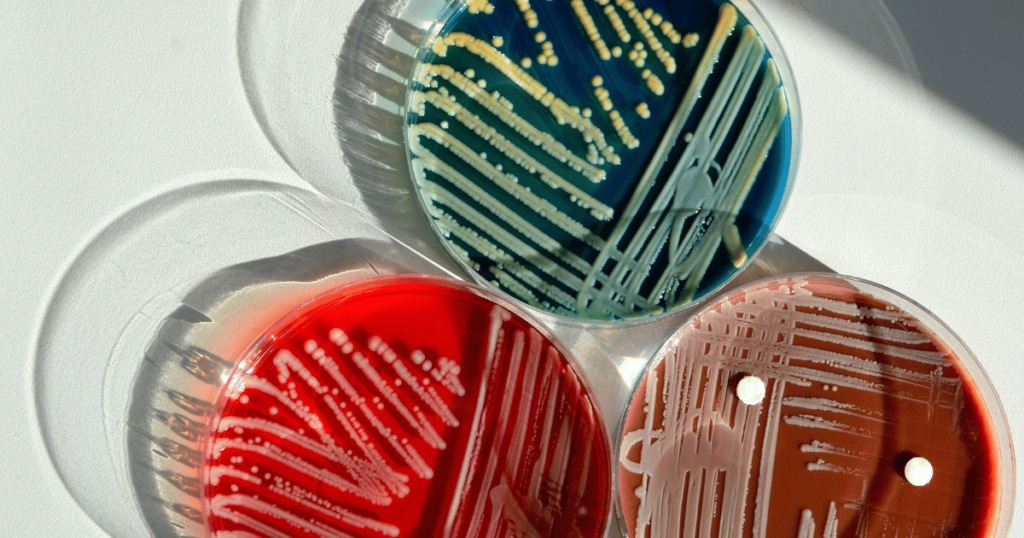

Bacterial filters are essential for encouraging environmentally friendly activities and maintaining public health safety in a time when sustainability and health are of the utmost importance. Leading the way in the development of bacterial filter technology, GVS Malaysia not only cleans air and water but also makes a substantial contribution to environmentally friendly activities. This paper examines the critical role that bacterial filters play in accomplishing these objectives.
Enhancing Air Quality
Bacterial filters are essential for improving indoor air quality by trapping and eliminating harmful bacteria and other pollutants. These filters are used in HVAC systems, air purifiers, and other ventilation solutions, effectively reducing the presence of airborne pathogens. For environments like hospitals, schools, and office buildings, where clean air is critical, bacterial filters help in maintaining a healthy indoor atmosphere, thus contributing to overall well-being and productivity.
Reducing Environmental Impact
One of the lesser-known benefits of using high-quality bacterial filters, like those offered by GVS Malaysia, is their contribution to reducing environmental impact. By improving the efficiency of HVAC systems through enhanced air filtration, these filters reduce energy consumption. Less energy usage means fewer carbon emissions, which is crucial in the fight against climate change. Furthermore, bacterial filters help extend the lifespan of HVAC systems by preventing the buildup of harmful particles that can cause wear and tear, thus reducing waste and the need for frequent replacements.
Supporting Water Purification Efforts
Bacterial filters are also used in water purification systems to remove contaminants and pathogens, making water safe for drinking and other uses. In Malaysia, where water conservation and quality are increasingly important, using bacterial filters helps in recycling and treating water without the extensive use of chemicals. This method supports sustainable water management practices by ensuring clean water supply without depleting natural resources.
Promoting Public Health
By filtering out harmful bacteria and other microorganisms, bacterial filters play a direct role in preventing diseases associated with poor air and water quality. This aspect is especially vital in densely populated areas where the risk of disease spread is higher. GVS Malaysia’s bacterial filters are designed to meet rigorous health standards, providing an additional layer of protection in public spaces, thus contributing to the broader public health infrastructure.
Economic Benefits
Implementing bacterial filters can lead to significant economic benefits over time. Facilities that use these filters often see a decrease in health-related absenteeism and an increase in productivity, which can translate to better economic outputs. Additionally, the cost savings from reduced energy consumption and lower maintenance needs for HVAC and water purification systems can be substantial, making bacterial filters a smart investment for businesses looking to enhance their sustainability profile.
Conclusion
More than just parts of air and water systems, bacterial filters are essential to building sustainable settings that advance both economic and public health. The importance of bacterial filters for environmental sustainability grows as GVS Malaysia innovates further in this area, underscoring the necessity of ongoing funding and widespread adoption of this technology.